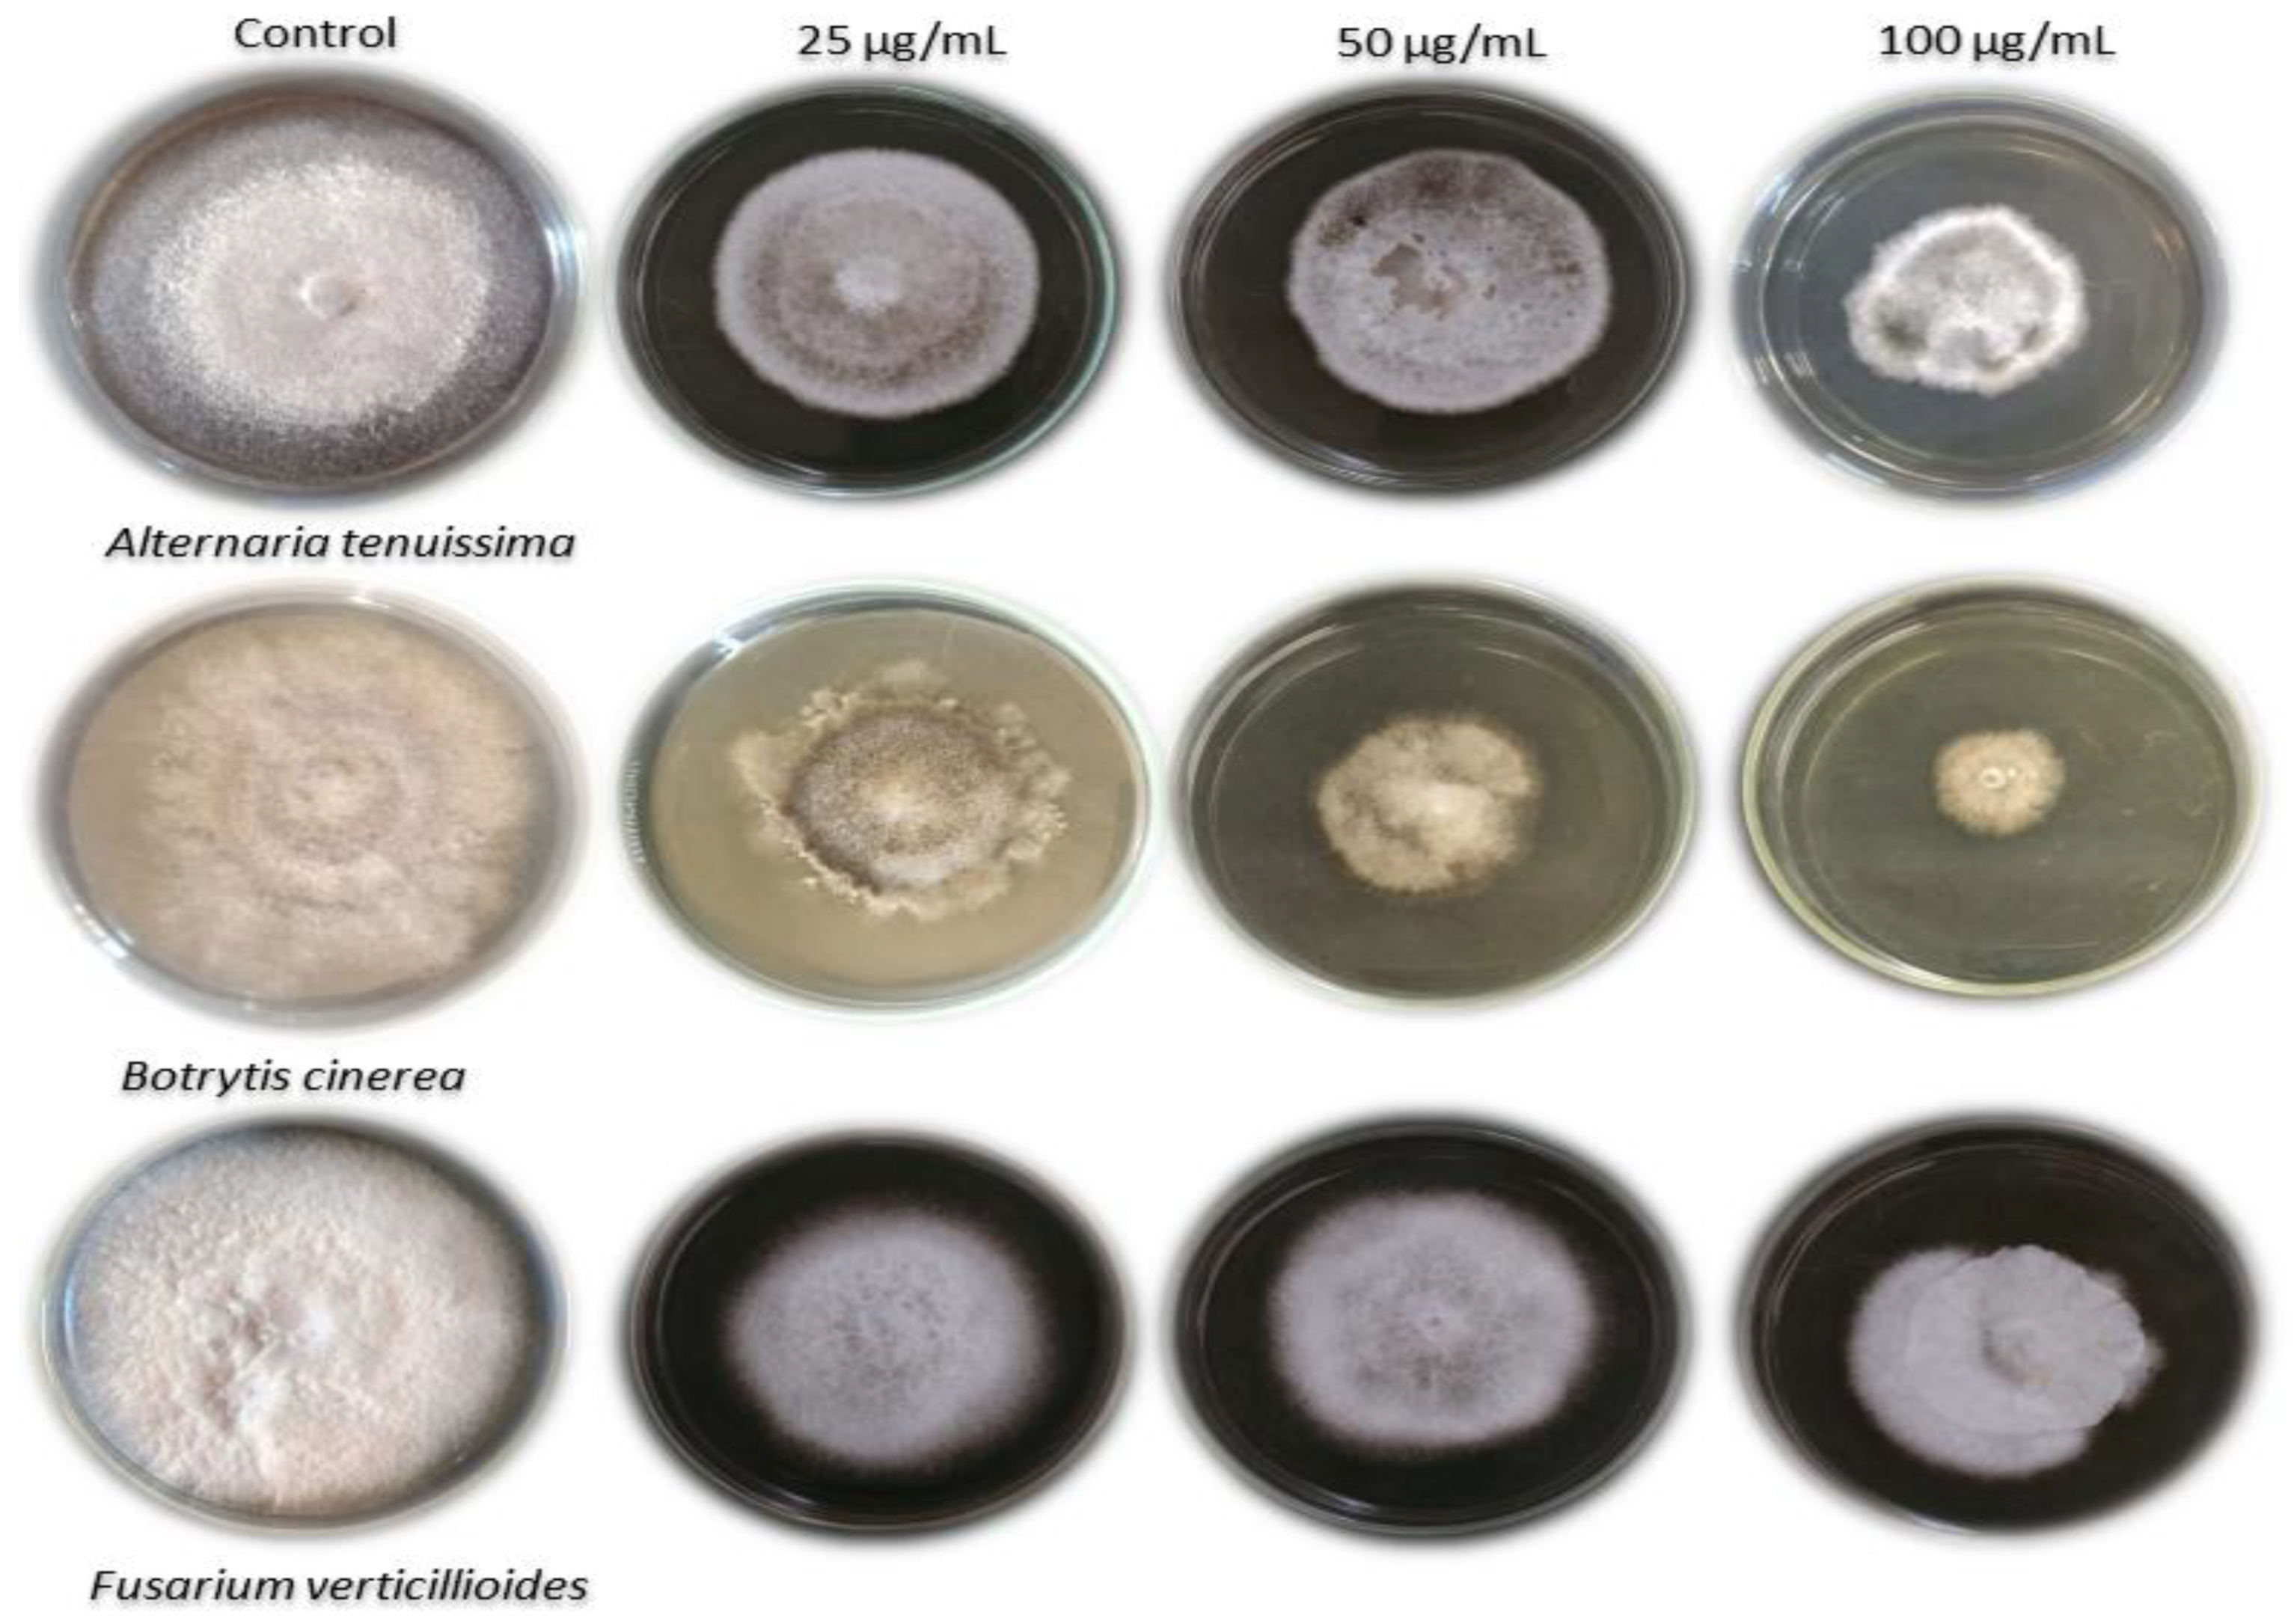
Sustainability 14 12799 g004 Sustainability 14 12799 g004

Antiviral and Antifungal of Ulva fasciata Extract: HPLC Analysis of Polyphenolic Compounds
Abstract
1. Introduction
2. Materials and Methods
2.1. Sampling Site
2.2. Preparation of Dried Algal Biomass
2.3. Extraction of Ulva fasciata Biomass
2.4. Viral Source and Antiviral Activity Assays
2.5. Ulva fasciata Extract Antifungal Assay
2.5.1. Isolation of Fungi
2.5.2. Nuclear Ribosomal Internal Transcribed Spacer (ITS) Region Amplification in Fungi
2.5.3. Antifungal Assay
2.6. HPLC Analysis
2.7. Data Analysis
3. Results
3.1. Antiviral Activity Assay of U. fasciata Extract
3.2. Ulva fasciata Extract Activity against the Fungi
3.2.1. Fungal Pathogens used and Initial Morphological Identification
3.2.2. ITS Molecular Identification
3.2.3. Ulva fasciata Extract Antifungal Activity
3.3. HPLC Analysis of the Phenolic and Flavonoid Compounds
4. Discussion
5. Conclusions
Author Contributions
Funding
Institutional Review Board Statement
Informed Consent Statement
Data Availability Statement
Acknowledgments
Conflicts of Interest
References
- Abdelkhalek, A.; Hafez, E. Plant Viral Diseases in Egypt and Their Control. In Cottage Industry of Biocontrol Agents and Their Applications; Springer: Berlin/Heidelberg, Germany, 2020; pp. 403–421. [Google Scholar]
- Abdelkhalek, A.; Behiry, S.I.; Al-Askar, A.A. Bacillus velezensis PEA1 Inhibits Fusarium oxysporum Growth and Induces Systemic Resistance to Cucumber Mosaic Virus. Agronomy 2020, 10, 1312. [Google Scholar] [CrossRef]
- Abdelkhalek, A. Expression of tomato pathogenesis related genes in response to Tobacco mosaic virus. JAPS J. Anim. Plant Sci. 2019, 29, 1596–1602. [Google Scholar]
- Scholthof, K.G.; Adkins, S.; Czosnek, H.; Palukaitis, P.; Jacquot, E.; Hohn, T.; Hohn, B.; Saunders, K.; Candresse, T.; Ahlquist, P. Top 10 plant viruses in molecular plant pathology. Mol. Plant Pathol. 2011, 12, 938–954. [Google Scholar] [CrossRef] [PubMed]
- Abdelkhalek, A.; Salem, M.Z.M.; Ali, H.M.; Kordy, A.M.; Salem, A.Z.M.; Behiry, S.I. Antiviral, antifungal, and insecticidal activities of Eucalyptus bark extract: HPLC analysis of polyphenolic compounds. Microb. Pathog. 2020, 147, 104383. [Google Scholar] [CrossRef] [PubMed]
- Heflish, A.A.; Abdelkhalek, A.; Al-Askar, A.A.; Behiry, S.I. Protective and Curative Effects of Trichoderma asperelloides Ta41 on Tomato Root Rot Caused by Rhizoctonia solani Rs33. Agronomy 2021, 11, 1162. [Google Scholar] [CrossRef]
- Oraby, S.A.M.; Radwan, R.I.M.; Ibrahim, S.A.; Hefny, R.M. Economic Study of Tomato Crop in Egypt WITH Referening to the Situation in North Sinai. Sinai J. Appl. Sci. 2017, 6, 223–234. [Google Scholar]
- Elsharkawy, M.M.; El-Okkiah, S.; Elsadany, A.Y.; Bedier, M.Y.; Omara, R.I.; Behiry, S.I.; Hassan, S.; Abdelkhalek, A. Systemic resistance induction of tomato plants against tomato mosaic virus by microalgae. Egypt. J. Biol. Pest Control 2022, 32, 1–7. [Google Scholar] [CrossRef]
- Mansour, M.M.A.; Salem, M.Z.M.; Khamis, M.H.; Ali, H.M. Natural durability of Citharexylum spinosum and Morus alba woods against three mold fungi. BioResources 2015, 10, 5330–5344. [Google Scholar] [CrossRef][Green Version]
- Abd El-Rahim, W.M.; Khalil, W.K.B.; Eshak, M.G. Genotoxicity studies on the removal of a direct textile dye by a fungal strain, in vivo, using micronucleus and RAPD-PCR techniques on male rats. J. Appl. Toxicol. 2008, 28, 484–490. [Google Scholar] [CrossRef]
- Behiry, S.I.; Soliman, S.A.; Al-Askar, A.A.; Alotibi, F.O.; Basile, A.; Abdelkhalek, A.; Elsharkawy, M.M.; Salem, M.Z.M.; Hafez, E.E.; Heflish, A.A. Plantago lagopus extract as a green fungicide induces systemic resistance against Rhizoctonia root rot disease in tomato plants. Front. Plant Sci. 2022, 13, 2818. [Google Scholar] [CrossRef]
- Roux, F.; Voisin, D.; Badet, T.; Balagué, C.; Barlet, X.; Huard-Chauveau, C.; Roby, D.; Raffaele, S. Resistance to phytopathogens e tutti quanti: Placing plant quantitative disease resistance on the map. Mol. Plant Pathol. 2014, 15, 427–432. [Google Scholar] [CrossRef] [PubMed]
- Rozlianah, F.S.; Sariah, M. Characterization of Malaysian isolates of Fusarium from tomato and pathogenicity testing. Res. J. Microbiol. 2010, 5, 926–932. [Google Scholar]
- Agamy, R.; Alamri, S.; Moustafa, M.F.M.; Hashem, M. Management of tomato leaf spot caused by Alternaria tenuissima Wiltshire using salicylic acid and Agrileen. Int. J. Agric. Biol. 2013, 15, 266–272. [Google Scholar]
- Sarven, M.S.; Hao, Q.; Deng, J.; Yang, F.; Wang, G.; Xiao, Y.; Xiao, X. Biological control of tomato gray mold caused by Botrytis cinerea with the entomopathogenic fungus Metarhizium anisopliae. Pathogens 2020, 9, 213. [Google Scholar] [CrossRef]
- Aslam, S.; Tahir, A.; Aslam, M.F.; Alam, M.W.; Shedayi, A.A.; Sadia, S. Recent advances in molecular techniques for the identification of phytopathogenic fungi—A mini review. J. Plant Interact. 2017, 12, 493–504. [Google Scholar] [CrossRef]
- Gazis, R.; Rehner, S.; Chaverri, P. Species delimitation in fungal endophyte diversity studies and its implications in ecological and biogeographic inferences. Mol. Ecol. 2011, 20, 3001–3013. [Google Scholar] [CrossRef]
- Chehri, K. Molecular identification of pathogenic Fusarium species, the causal agents of tomato wilt in western Iran. J. Plant Prot. Res. 2016, 56, 143–148. [Google Scholar] [CrossRef]
- Stracquadanio, C.; Luz, C.; La Spada, F.; Meca, G.; Cacciola, S.O. Inhibition of mycotoxigenic fungi in different vegetable matrices by extracts of Trichoderma species. J. Fungi 2021, 7, 445. [Google Scholar] [CrossRef]
- CHANG, Y.; Bin, D.U.; Ling, W.; Pei, J.I.; XIE, Y.; LI, X.; LI, Z.; WANG, J. A study on the pathogen species and physiological races of tomato Fusarium wilt in Shanxi, China. J. Integr. Agric. 2018, 17, 1380–1390. [Google Scholar] [CrossRef]
- Abdelkhalek, A.; Al-Askar, A.A.; Elbeaino, T.; Moawad, H.; El-Gendi, H. Protective and Curative Activities of Paenibacillus polymyxa against Zucchini yellow mosaic virus Infestation in Squash Plants. Biology 2022, 11, 1150. [Google Scholar] [CrossRef]
- Baloch, G.N.; Tariq, S.; Ehteshamul-Haque, S.; Athar, M.; Sultana, V.; Ara, J. Management of root diseases of eggplant and watermelon with the application of asafoetida and seaweeds. J. Appl. Bot. Food Qual. 2013, 86, 138–142. [Google Scholar]
- Pourakbar, L.; Moghaddam, S.S.; Enshasy, H.A.; El Sayyed, R.Z. Antifungal activity of the extract of a macroalgae, Gracilariopsis persica, against four plant pathogenic fungi. Plants 2021, 10, 1781. [Google Scholar] [CrossRef] [PubMed]
- Mostafa, Y.S.; Alamri, S.A.; Alrumman, S.A.; Hashem, M.; Taher, M.A.; Baka, Z.A. In Vitro and In Vivo Biocontrol of Tomato Fusarium Wilt by Extracts from Brown, Red, and Green Macroalgae. Agriculture 2022, 12, 345. [Google Scholar] [CrossRef]
- Khan, A.M.; Naz, S.; Abid, M. Evaluation of marine red alga Melanothamnus afaqhusainii against Meloidogyne incognita, fungus and as fertilizing potential on okra. Pak. J. Nematol 2016, 34, 91–100. [Google Scholar]
- Jiménez, E.; Dorta, F.; Medina, C.; Ramírez, A.; Ramírez, I.; Peña-Cortés, H. Anti-phytopathogenic activities of macro-algae extracts. Mar. Drugs 2011, 9, 739–756. [Google Scholar] [CrossRef]
- Umen, J.G. Green algae and the origins of multicellularity in the plant kingdom. Cold Spring Harb. Perspect. Biol. 2014, 6, a016170. [Google Scholar] [CrossRef]
- Michalak, I.; Chojnacka, K. Algae as production systems of bioactive compounds. Eng. Life Sci. 2015, 15, 160–176. [Google Scholar] [CrossRef]
- Hayden, H.S.; Blomster, J.; Maggs, C.A.; Silva, P.C.; Stanhope, M.J.; Waaland, J.R. Linnaeus was right all along: Ulva and Enteromorpha are not distinct genera. Eur. J. Phycol. 2003, 38, 277–294. [Google Scholar] [CrossRef]
- Koyanagi, S.; Tanigawa, N.; Nakagawa, H.; Soeda, S.; Shimeno, H. Oversulfation of fucoidan enhances its anti-angiogenic and antitumor activities. Biochem. Pharmacol. 2003, 65, 173–179. [Google Scholar] [CrossRef]
- Costa, L.S.; Fidelis, G.P.; Cordeiro, S.L.; Oliveira, R.M.; de Sabry, D.A.; Câmara, R.B.G.; Nobre, L.T.D.B.; Costa, M.S.S.P.; Almeida-Lima, J.; Farias, E.H.C. Biological activities of sulfated polysaccharides from tropical seaweeds. Biomed. Pharmacother. 2010, 64, 21–28. [Google Scholar] [CrossRef]
- Al-Malki, A.L. In vitro cytotoxicity and pro-apoptotic activity of phycocyanin nanoparticles from Ulva lactuca (Chlorophyta) algae. Saudi J. Biol. Sci. 2020, 27, 894–898. [Google Scholar] [CrossRef] [PubMed]
- Londo, G. The decimal scale for relevés of permanent quadrats. In Sampling Methods and Taxon Analysis in Vegetation Science: Releve Surveys,‘Vegetationsaufnahmen’, Floristic Analysis of Plant Communities; Junk: Pretoria, South Africa, 1984; pp. 45–49. [Google Scholar]
- Böer, B.; Warnken, J. Flora of the Jubail Marine Wildlife Sanctuary, Saudi Arabia. A Mar. Wildl. Sanctuary Arab. Gulf. Environ. Res. Conserv. Follow. 1991, 290–301. [Google Scholar]
- Komárek, J.; Zapomělová, E. Planktic morphospecies of the cyanobacterial genus Anabaena= subg. Dolichospermum–1. part: Coiled types. Fottea 2007, 7, 1–31. [Google Scholar] [CrossRef]
- Gooding, G.V., Jr.; Hebert, T.T. A simple technique for purification of tobacco mosaic virus in large quantities. Phytopathology 1967, 57, 1285. [Google Scholar]
- Abdelkhalek, A.; Ismail, I.A.I.A.; Dessoky, E.S.E.S.; El-Hallous, E.I.E.I.; Hafez, E. A tomato kinesin-like protein is associated with Tobacco mosaic virus infection. Biotechnol. Biotechnol. Equip. 2019, 33, 1424–1433. [Google Scholar] [CrossRef]
- Dhingra, O.D.; Sinclair, J.B. Basic Plant Pathology Methods; CRC Press: Boca Raton, FL, USA, 2017; ISBN 1315138131. [Google Scholar]
- White, T.J.; Bruns, T.; Lee, S.; Taylor, J. Amplification and direct sequencing of fungal ribosomal RNA genes for phylogenetics. PCR Protoc. Guid. Methods Appl. 1990, 18, 315–322. [Google Scholar]
- Schimitz, H. Poisoned food technique Industrial and Engineering Chemistry Analyst. Ed 1930, 2, 361. [Google Scholar]
- Strange, R.N.; Scott, P.R. Plant disease: A threat to global food security. Annu. Rev. Phytopathol. 2005, 43, 83–116. [Google Scholar] [CrossRef]
- Omar, A.Z.; Hamdy, E.; Hamed, E.A.; Hafez, E.; Abdelkhalek, A. The curative activity of some arylidene dihydropyrimidine hydrazone against Tobacco mosaic virus infestation. J. Saudi Chem. Soc. 2022, 26, 101504. [Google Scholar] [CrossRef]
- Abdelkhalek, A.; Al-Askar, A.A.; Behiry, S.I. Bacillus licheniformis strain POT1 mediated polyphenol biosynthetic pathways genes activation and systemic resistance in potato plants against Alfalfa mosaic virus. Sci. Rep. 2020, 10, 1–16. [Google Scholar] [CrossRef]
- Alengebawy, A.; Abdelkhalek, S.T.; Qureshi, S.R.; Wang, M.-Q. Heavy Metals and Pesticides Toxicity in Agricultural Soil and Plants: Ecological Risks and Human Health Implications. Toxics 2021, 9, 42. [Google Scholar] [CrossRef] [PubMed]
- El-Gendi, H.; Al-Askar, A.A.; Király, L.; Samy, M.A.; Moawad, H.; Abdelkhalek, A. Foliar Applications of Bacillus subtilis HA1 Culture Filtrate Enhance Tomato Growth and Induce Systemic Resistance against Tobacco mosaic virus Infection. Horticulturae 2022, 8, 301. [Google Scholar] [CrossRef]
- Pérez, M.J.; Falqué, E.; Domínguez, H. Antimicrobial action of compounds from marine seaweed. Mar. Drugs 2016, 14, 52. [Google Scholar] [CrossRef] [PubMed]
- Gross, E.M.; Hilt, S.; Lombardo, P.; Mulderij, G. Searching for allelopathic effects of submerged macrophytes on phytoplankton—state of the art and open questions. In Shallow Lakes in a Changing World; Netherlands Institute of Ecology: Nieuwersluis, The Netherands, 2007; pp. 77–88. [Google Scholar]
- Mulderij, G.; Mooij, W.M.; Smolders, A.J.P.; Van Donk, E. Allelopathic inhibition of phytoplankton by exudates from Stratiotes aloides. Aquat. Bot. 2005, 82, 284–296. [Google Scholar] [CrossRef]
- Mofeed, J.; Deyab, M.; Mohamed, A.; Moustafa, M.; Negm, S.; El-Bilawy, E. Antimicrobial activities of three seaweeds extract against some human viral and bacterial pathogens. Biocell 2022, 46, 247. [Google Scholar] [CrossRef]
- Mishra, B.; Tiwari, A.; Mahmoud, A.E.D. Microalgal potential for sustainable aquaculture applications: Bioremediation, biocontrol, aquafeed. Clean Technol. Environ. Policy 2022, 1–13. [Google Scholar] [CrossRef]
- Abd El-Baky, H.H.; El-Baz, F.K.; El-Baroty, G.S. Natural preservative ingredient from marine alga Ulva lactuca L. Int. J. food Sci. Technol. 2009, 44, 1688–1695. [Google Scholar] [CrossRef]
- Valko, M.; Izakovic, M.; Mazur, M.; Rhodes, C.J.; Telser, J. Role of oxygen radicals in DNA damage and cancer incidence. Mol. Cell. Biochem. 2004, 266, 37–56. [Google Scholar] [CrossRef]
- Nimse, S.B.; Pal, D. Free radicals, natural antioxidants, and their reaction mechanisms. RSC Adv. 2015, 5, 27986–28006. [Google Scholar] [CrossRef]
- Peasura, N.; Laohakunjit, N.; Kerdchoechuen, O.; Vongsawasdi, P.; Chao, L.K. Assessment of biochemical and immunomodulatory activity of sulphated polysaccharides from Ulva intestinalis. Int. J. Biol. Macromol. 2016, 91, 269–277. [Google Scholar] [CrossRef]
- Kidgell, J.T.; Magnusson, M.; de Nys, R.; Glasson, C.R.K. Ulvan: A systematic review of extraction, composition and function. Algal Res. 2019, 39, 101422. [Google Scholar] [CrossRef]
- Gunathilake, T.; Akanbi, T.O.; Suleria, H.A.R.; Nalder, T.D.; Francis, D.S.; Barrow, C.J. Seaweed phenolics as natural antioxidants, aquafeed additives, veterinary treatments and cross-linkers for microencapsulation. Mar. Drugs 2022, 20, 445. [Google Scholar] [CrossRef] [PubMed]
- Farasat, M.; Khavari-Nejad, R.-A.; Nabavi, S.M.B.; Namjooyan, F. Antioxidant activity, total phenolics and flavonoid contents of some edible green seaweeds from northern coasts of the Persian Gulf. Iran. J. Pharm. Res. 2014, 13, 163. [Google Scholar] [PubMed]
- Li, Z.; Wang, B.; Zhang, Q.; Qu, Y.; Xu, H.; Li, G. Preparation and antioxidant property of extract and semipurified fractions of Caulerpa racemosa. J. Appl. Phycol. 2012, 24, 1527–1536. [Google Scholar] [CrossRef]
- Elmosallamy, A.M.D.; Amer, T.N.; Mohamed, S.Z.; Ali, Y.M.; Hussein, S.A.A. Phytochemical Constituents of Ulva lactuca and Supplementation to Improve the Nile Tilapia (Oreochromis Niloticus) Haemato-Biochemical Status. Egypt. J. Chem. 2021, 64, 2663–2670. [Google Scholar] [CrossRef]
- Guardia, T.; Rotelli, A.E.; Juarez, A.O.; Pelzer, L.E. Anti-inflammatory properties of plant flavonoids. Effects of rutin, quercetin and hesperidin on adjuvant arthritis in rat. Il Farm. 2001, 56, 683–687. [Google Scholar] [CrossRef]
- Shahzad, G.-R.; Passera, A.; Maldera, G.; Casati, P.; Marcello, I.; Bianco, P.A. Biocontrol Potential of Endophytic Plant-Growth-Promoting Bacteria against Phytopathogenic Viruses: Molecular Interaction with the Host Plant and Comparison with Chitosan. Int. J. Mol. Sci. 2022, 23, 6990. [Google Scholar] [CrossRef]
- Abdelkhalek, A.; Aseel, D.G.; Király, L.; Künstler, A.; Moawad, H.; Al-Askar, A.A. Induction of Systemic Resistance to Tobacco mosaic virus in Tomato through Foliar Application of Bacillus amyloliquefaciens Strain TBorg1 Culture Filtrate. Viruses 2022, 14, 1830. [Google Scholar] [CrossRef] [PubMed]
- Waziri, H.M.A. Plants as antiviral agents. J. Plant Pathol. Microbiol. 2015, 6, 1. [Google Scholar] [CrossRef]
- Mani, J.S.; Johnson, J.B.; Steel, J.C.; Broszczak, D.A.; Neilsen, P.M.; Walsh, K.B.; Naiker, M. Natural product-derived phytochemicals as potential agents against coronaviruses: A review. Virus Res. 2020, 284, 197989. [Google Scholar] [CrossRef]
- Shaygannia, E.; Bahmani, M.; Zamanzad, B.; Rafieian-Kopaei, M. A review study on Punica granatum L. J. Evid. Based. Complementary Altern. Med. 2016, 21, 221–227. [Google Scholar] [CrossRef] [PubMed]
- Davidson, P.M.; Taylor, T.M.; Schmidt, S.E. Chemical preservatives and natural antimicrobial compounds. In Food Microbiology: Fundamentals and Frontiers, 4th ed.; ASM Press: Washington, DC, USA, 2014; pp. 765–801. [Google Scholar]
- Kumar, N.; Pruthi, V. Potential applications of ferulic acid from natural sources. Biotechnol. Rep. 2014, 4, 86–93. [Google Scholar] [CrossRef]
- Likić, S.; Šola, I.; Ludwig-Müller, J.; Rusak, G. Involvement of kaempferol in the defence response of virus infected Arabidopsis thaliana. Eur. J. Plant Pathol. 2014, 138, 257–271. [Google Scholar] [CrossRef]
- Fan, W.; Qian, S.; Qian, P.; Li, X. Antiviral activity of luteolin against Japanese encephalitis virus. Virus Res. 2016, 220, 112–116. [Google Scholar] [CrossRef] [PubMed]
- Wang, R.Y.-L.; Stork, J.; Nagy, P.D. A key role for heat shock protein 70 in the localization and insertion of tombusvirus replication proteins to intracellular membranes. J. Virol. 2009, 83, 3276–3287. [Google Scholar] [CrossRef] [PubMed]
- Wang, J.; Hao, K.; Yu, F.; Shen, L.; Wang, F.; Yang, J.; Su, C. Field application of nanoliposomes delivered quercetin by inhibiting specific hsp70 gene expression against plant virus disease. J. Nanobiotechnol. 2022, 20, 1–16. [Google Scholar] [CrossRef] [PubMed]
- Mahfuz, S.; Mun, H.-S.; Dilawar, M.A.; Ampode, K.M.B.; Yang, C.-J. Potential Role of Protocatechuic Acid as Natural Feed Additives in Farm Animal Production. Animals 2022, 12, 741. [Google Scholar] [CrossRef]
- Li, T.; Huang, Y.; Xu, Z.-S.; Wang, F.; Xiong, A.-S. Salicylic acid-induced differential resistance to the Tomato yellow leaf curl virus among resistant and susceptible tomato cultivars. BMC Plant Biol. 2019, 19, 1–14. [Google Scholar] [CrossRef] [PubMed]
- Abdelkhalek, A.; Al-Askar, A.A.; Alsubaie, M.M.; Behiry, S.I. First Report of Protective Activity of Paronychia argentea Extract against Tobacco Mosaic Virus Infection. Plants 2021, 10, 2435. [Google Scholar] [CrossRef] [PubMed]
- Mwangi, M.W.; Muiru, W.M.; Kimenju, J.W. Characterisation of Fusarium species infecting tomato in Mwea West Sub-county, Kirinyaga County, Kenya. Can. J. Plant Pathol. 2021, 43, 56–61. [Google Scholar] [CrossRef]
- Akbar, A.; Hussain, S.; Ali, G.S. Germplasm evaluation of tomato for resistance to the emerging wilt pathogen Fusarium equiseti. J. Agric. Stud 2018, 5, 174. [Google Scholar] [CrossRef]
- Akbar, A.; Hussain, S.; Ullah, K.; Fahim, M.; Ali, G.S. Detection, virulence and genetic diversity of Fusarium species infecting tomato in Northern Pakistan. PLoS ONE 2018, 13, e0203613. [Google Scholar] [CrossRef] [PubMed]
- Lotfi, A.; Kottb, M.; Elsayed, A.; Shafik, H. Antifungal activity of some Mediterranean seaweed against Macrophomina phaseolina and Fusarium oxysporum in Vitro. Alfarama J. Basic Appl. Sci. 2021, 2, 81–96. [Google Scholar] [CrossRef]
- Selim, R.E.; Ahmed, S.M.; El-Zemity, S.R.; Ramses, S.S.; Moustafa, Y.T.A. Antifungal activity and seasonal variation of green alga (Ulva lactuca) extracts. Asian J. Agric. Food Sci. 2015, 3, 419–427. [Google Scholar]
- Osman, M.E.H.; Abushady, A.M.; Elshobary, M.E. In vitro screening of antimicrobial activity of extracts of some macroalgae collected from Abu-Qir bay Alexandria, Egypt. African J. Biotechnol. 2010, 9, 7203–7208. [Google Scholar]
- Kosanić, M.; Ranković, B.; Stanojković, T. Biological activities of two macroalgae from Adriatic coast of Montenegro. Saudi J. Biol. Sci. 2015, 22, 390–397. [Google Scholar] [CrossRef] [PubMed]

| Concentration (µg/mL) | % of Inhibition | ||
|---|---|---|---|
| Botrytis cinerea | Fusarium verticillioides | Alternaria tenuissima | |
| Control | 00.00 ± 0.00 c * | 00.00 ± 0.00 b | 00.00 ± 0.00 c |
| 25 | 52.96 ± 1.24 b | 46.67 ± 1.16 a | 39.63 ± 2.12 b |
| 50 | 59.26 ± 2.01 b | 48.89 ± 1.89 a | 43.33 ± 1.99 b |
| 100 | 69.26 ± 1.53 a | 51.85 ± 1.75 a | 55.93 ± 1.69 a |
| Phenolic Compounds | Flavonoid Compounds | ||||
|---|---|---|---|---|---|
| Compound | Retention Time | Concentration (µg/mL) | Compound | Retention Time | Concentration (µg/mL) |
| Caffeic acid | 4.4 | 0.56 | Rutin | 4.8 | 7.62 |
| Ferulic acid | 5.0 | 9.05 | Quercetin | 6.9 | 6.99 |
| Chlorogenic acid | 7.89 | 6.36 | Kaempferol | 8.0 | 3.25 |
| 4-Hydroxybenzoic acid | 9.2 | 12.33 | Luteolin | 8.8 | 4.14 |
| Salicylic acid | 11.0 | 0.78 | 7-Hydroxyflavone | 10.0 | 12.45 |
| Ellagic acid | 12.2 | 1.09 | |||
| Protocatechuic acid | 14.2 | 0.09 | |||
Publisher’s Note: MDPI stays neutral with regard to jurisdictional claims in published maps and institutional affiliations. |
© 2022 by the authors. Licensee MDPI, Basel, Switzerland. This article is an open access article distributed under the terms and conditions of the Creative Commons Attribution (CC BY) license (https://creativecommons.org/licenses/by/4.0/).
Share and Cite
El-Bilawy, E.H.; Al-Mansori, A.-N.A.; Alotibi, F.O.; Al-Askar, A.A.; Arishi, A.A.; Teiba, I.I.; Sabry, A.E.-N.; Elsharkawy, M.M.; Heflish, A.A.; Behiry, S.I.; et al. Antiviral and Antifungal of Ulva fasciata Extract: HPLC Analysis of Polyphenolic Compounds. Sustainability 2022, 14, 12799. https://doi.org/10.3390/su141912799
El-Bilawy EH, Al-Mansori A-NA, Alotibi FO, Al-Askar AA, Arishi AA, Teiba II, Sabry AE-N, Elsharkawy MM, Heflish AA, Behiry SI, et al. Antiviral and Antifungal of Ulva fasciata Extract: HPLC Analysis of Polyphenolic Compounds. Sustainability. 2022; 14(19):12799. https://doi.org/10.3390/su141912799
Chicago/Turabian StyleEl-Bilawy, Emad H., Al-Naji A. Al-Mansori, Fatimah O. Alotibi, Abdulaziz A. Al-Askar, Amr A. Arishi, Islam I. Teiba, Abd El-Naser Sabry, Mohsen Mohamed Elsharkawy, Ahmed A. Heflish, Said I. Behiry, and et al. 2022. "Antiviral and Antifungal of Ulva fasciata Extract: HPLC Analysis of Polyphenolic Compounds" Sustainability 14, no. 19: 12799. https://doi.org/10.3390/su141912799
APA StyleEl-Bilawy, E. H., Al-Mansori, A.-N. A., Alotibi, F. O., Al-Askar, A. A., Arishi, A. A., Teiba, I. I., Sabry, A. E.-N., Elsharkawy, M. M., Heflish, A. A., Behiry, S. I., & Abdelkhalek, A. (2022). Antiviral and Antifungal of Ulva fasciata Extract: HPLC Analysis of Polyphenolic Compounds. Sustainability, 14(19), 12799. https://doi.org/10.3390/su141912799

